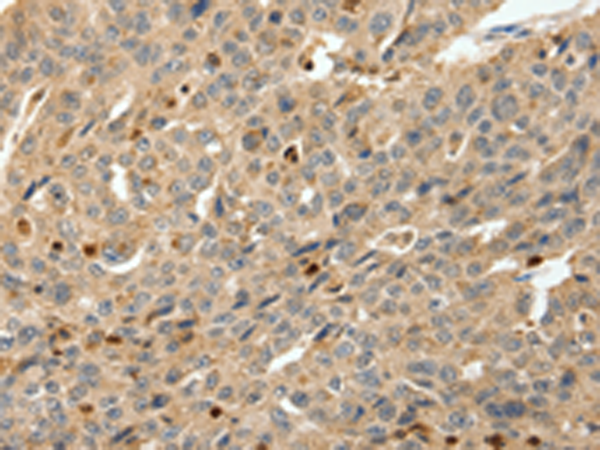
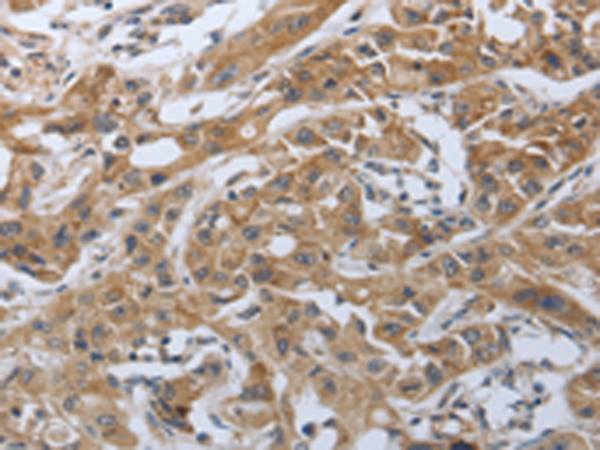
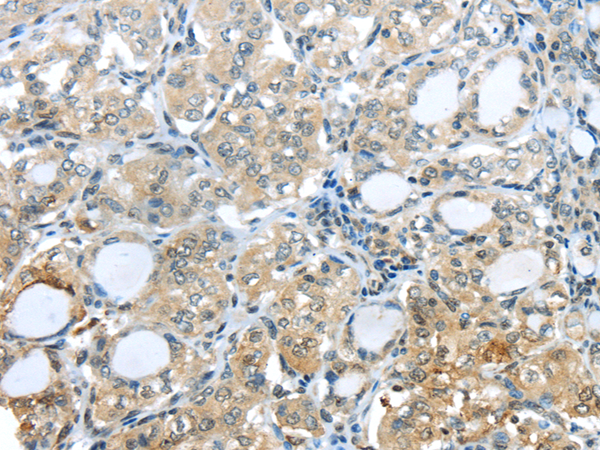

-
分类: 科研抗体货号: P04438别名: ROS; MCF3; c-ros-1应用: IHC反应种属: Human
-
分类: 科研抗体货号: P04384别名: NIS; TDH1应用: WB,IHC反应种属: Human
-
分类: 科研抗体货号: P04420别名: PRKAR1应用: WB,IHC反应种属: Human, Mouse, Rat
-
分类: 科研抗体货号: P04437别名: 42A, 18A2, CAPL, FSP1, MTS1, P9KA, PEL98应用: IHC反应种属: Human
-
分类: 科研抗体货号: P04383别名: NGX6, NAG-5, C9orf127, RP11-112J3.10应用: IHC反应种属: Human, Mouse
-
分类: 科研抗体货号: P04417别名: PD1, PD-1, CD279, SLEB2, hPD-1, hPD-l应用: IHC反应种属: Human
-
分类: 科研抗体货号: P04432别名: HARP, HBNF, HBGF8, NEGF1应用: WB反应种属: Human, Mouse, Rat
-
分类: 科研抗体货号: P04382别名: NGN2, Atoh4, ngn-2, Math4A, bHLHa8应用: IHC反应种属: Human
-
分类: 科研抗体货号: P04410别名: bPAK; MRX30; MRX47; OPHN3; hPAK3; CDKN1A; PAK3beta应用: WB,IHC反应种属: Human, Mouse, Rat
-
分类: 科研抗体货号: P04430别名: S9, Rpn6, p44.5应用: IHC反应种属: Human, Mouse, Rat

鄂公网安备42018502007531号
鄂公网安备42018502007531号

